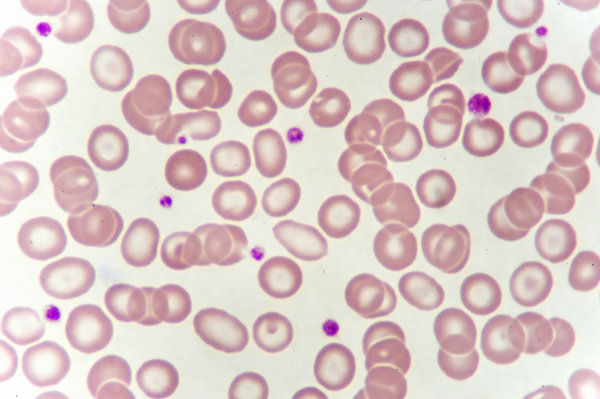
合并贫血放疗敏感性降低

龟头炎的预防工作要如何做好呢?
男人私处的每一个部位都是十分脆弱的。睾丸不能随意碰撞扭曲,阴囊一定要通风散热,阴茎要注意不能过度充血等等。今天,我们就来说一说容易被广大男性朋友忽略的龟头应该怎么样进行日常的卫生护理。在平时男性龟头炎的预防工作要如何做好呢,
龟头受到细菌侵袭就会出现龟头炎,所以我们一定要加以预防。预防工作的第一步就要从个人卫生做起,注意自己的私处清洁。尽可能每天都清洗一下自己的包皮褶皱和龟头,在洗澡的时候把包皮翻出来,露出龟头,用温水进行冲洗,不要让一些脏东西躲在包皮夹缝中滋生出细菌。在上厕所的时候,也要注意甩干净尿液再收回阴茎,避免尿液的残留在龟头上发酵引起细菌的繁殖。
个人的私处外部卫生工作做好了,在预防龟头炎的路上也就成功了一大半。接下来我们就要注意饮食上的清淡了,不要经常的食用辛辣刺激的食物,也应该尽量的少吃生冷寒凉的食物。这些食物都会对身体产生负面影响,引起血液循环的变慢,导致新陈代谢出现问题,身体毒素不能快速排出,从而影响生殖健康。
除了以上的预防之外,我们也要注意以下问题。如果夫妻之间有一方的性器官出现了炎症或者真菌疾病,就要停止房事生活,不要让细菌有交叉感染的机会。细菌感染的话,受害的部位首当其冲就是男性的龟头。同时也要注意性生活的频率和性交对象的专一。
龟头也像其他男性生殖部位一样,不仅脆弱,也十分容易被细菌侵袭。所以,在日常生活中,男性朋友一定要注意保护好龟头,穿宽松纯棉的内裤会让龟头舒服很多,也能让私处更加通风。卫生护理也是必不可少的一项日常工作,千万不要偷懒就不去清理私处,让细菌有机可乘。
大家都在看